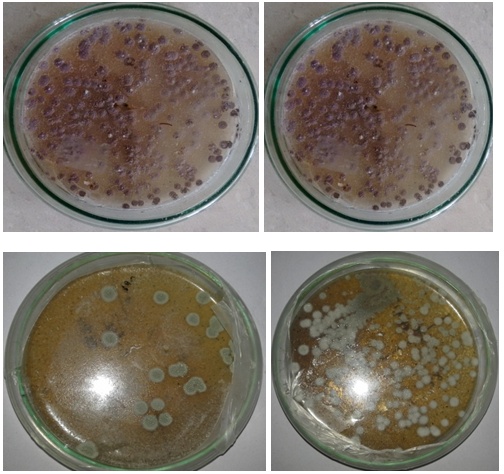

Int J Curr Pharm Res, Vol 9, Issue 1, 40-44Original Article
ISOLATION AND SCREENING OF NOVEL STREPTOMYCES FROM SEDIMENTS OF BAY OF BENGAL NEAR SRIKAKULAM COAST
SUJATHA PEELA, SWETHALATHA PORANA
Dept. of Biotechnology, Dr. B. R. Ambedkar University, Srikakulam, AP, India
Email: drpsujatha@gmail.com
Received: 22 Sep 2016, Revised and Accepted: 15 Nov 2016
ABSTRACT
Objective: The Objective of this research is to isolate and screen potent antibiotic producing actinomycetes from unexplored regions of Bay of Bengal Near Srikakulam Coast.
Methods: The isolation and screening were done on starch casein agar media. Antimicrobial activity screening was done using cross streak method and agar diffusion method. Further, Morphological characterization of the isolate was done using Scanning electron Microscopy (SEM-JSM 6610). Further, the cultural characterization of the isolates was done using standard protocols.
Results: A total of sixty-eight isolates of Actinomycetes were collected from marine sediments of coastal line of Srikakulam district of Andhra Pradesh, which is one of the longest coastal lines of Andhra Pradesh. Due to its longest coastal line and geographical distribution, there are promising chance of diversity of the microorganisms and antibiotic producing potential. Each isolate was tested against various bacteria. Among all the isolates twelve isolates were promising and showed good antimicrobial activity. Within twelve isolates the isolate A-10 was very promising and showed antibiotic potential against most of the tested bacteria. This isolate appears to produce high anti-bacterial compounds on potato dextrose agar and nutrient agar medium respectively by using the agar diffusion method. The potent Actinomycete A-10 was further characterised by morphological methods consist of macroscopic and microscopic methods. The mycelium structure, colour and arrangement of conidiophores were observed through the oil immersion (100X). The strain was grown on Starch-Casein agar medium for morphological study using Scanning Electron microscopy. Scanning Electron micrographs of the strain A-10 results that the spore chain was straight and with more than 20 spores per chain. The spores are cylindrical in shape and had a smooth surface. Whirls, sclerotic granules, sporangia and flagellate spores were not observed. Further various biochemical tests performed for the identification of potent isolates are as follows: Melanin reaction, H2S production, tyrosine reaction, starch hydrolysis, casein hydrolysis, gelatin hydrolysis, milk coagulation and peptonization, nitrate reduction, temperature range of growth, pH tolerance and cell wall type by comparing all these results with the Bergey’s manual of Determinative Bacteriology and the organisms were identified. The isolate was identified as Streptomyces sp.
Conclusion: Thus the result of antibacterial screening represents that the coastal area of Srikakulam is a potential source of antibiotic producing actinomycetes. Further the phylogenic tree construction and purification of the antibiotic principle from A-10 were under investigation.
Keywords: Actinomycetes, Marine Sediments, Starch-Casein agar, SEM
© 2017 The Authors. Published by Innovare Academic Sciences Pvt Ltd. This is an open access article under the CC BY license (http://creativecommons.org/licenses/by/4.0/)
DOI: http://dx.doi.org/10.22159/ijcpr.2017v9i1.16603
INTRODUCTION
Marine environments are a largely untapped source for the isolation of new microorganisms with the potentiality to produce active secondary metabolites. Among such microorganisms, actinomycetes are of special interest, since they are known to produce chemically diverse compounds with a wide range of unique and biologically active metabolites [1]. Therapeutically useful compounds and enzymes having application in industry Microorganisms in marine environments attract a great deal of attention, due to their adaptability to extreme environments and production of novel natural compounds [2]. Marine environmental conditions show great variation and are extremely different from terrestrial ones; hence marine actinomycetes have different characteristics from those of terrestrial counterparts. this allows the organisms to produce different type of bioactive compounds with unique properties and application Marine environment in the Bay of Bengal is believed to have rich microbial diversity and the vast pool of indigenous marine microflora is not fully Explored recent focuses on marine actinomycetes show that they are being extensively explored for the discovery of drugs and other bioactive metabolites, though reports are available on antibiotic production by marine actinomycetes [3]. The demand for new antibiotics continues to grow due to the rapid emergence of multi-drug resistant pathogens. Actinomycetes are free-living, saprophytic, filamentous bacteria. They found in soil, fresh and marine water environments. Actinomycetes have both fungal and bacterial features the number of actinomycetes are gram-positive, high G+C containing filamentous bacteria [4]. As marine, environmental conditions are extremely different from terrestrial ones. The marine actinomycetes are known to produce potential secondary metabolites which are biologically active. The present study was conducted to isolate and identify novel marine actinomycetes. As a part of our investigation, we have selected the unexplored area of the north coastal line of Andhra Pradesh i. e Srikakulam Coast for the isolation of potent actinomycetes. Srikakulam is one of the longest coastal line of Andhra Pradesh. Due to its longest coastal line and geographical distribution, there are promising chance of diversity of the microorganisms and antibiotic producing potential. The present study deals with isolation and screening potent actinomycetes from marine sediments collected from of Srikakulam Coast of Bay of Bengal
MATERIALS AND METHODS
Materials
Cultures were obtained from Microbial Type Culture Collection (MTCC), IMTECH, Chandigarh. All chemicals and media were obtained from Himedia.
Sampling procedure
In the course of screening for bioactive actinomycetes, altogether of 4 marine sediments were collected from the depth of 10-40 m in Bay Bengal near Srikakulam coast using a core sampler. They were transferred to the Laboratory in polypropylene Bags for further processing for isolation of Actinomycetes.
Isolation of actinomycetes colonies from the marine sediments
Isolation and Enumeration of Actinomycetes were performed by the soil dilution plate technique (Ellaiah et al.1996)using starch casein agar medium (g/l: Starch–10 grams, Casein-0.3 grms,KNO3-2 grams,Nacl-2garms, K2HPO4-2grams,MgSO4.7H2O-0.05grams,CaCo3-0.02grams,FeSO4.7H2O-0.01 grams, and Agar 18grams).50 ml of Starch casein agar media in 250 ml. flask were sterilized at 121o C for 20 min by autoclaving. The media was prepared by using 50% (v\v) sea water. 1g each of the marine sediments sample was taken in 250 ml Erlenmeyer flask containing 50 ml of sterile water the flasks were on a rotary shaker for 30 min for the detachment of spore chains the flasks were kept a side for 15 min. To settle down the particulate matter. The suspension was serially diluted 1 ml of each of 50 ml of starch casein agar media was supplemented with 25-µg/ml conc. of tetracycline and 75-µg/ml conc. of itraconazole, to minimise bacterial and fungal contamination respectively and thoroughly mixed and poured into Petri plates and incubated at 28 °c. The incubated Petri plates were observed from one week to three weeks after incubation actinomycetes colonies were marked. The identical colonies were scored out and the selected colonies were subcultured on Starch casein agar slants and incubated at 28 °C for one week.
Screening of antibiotic producing strains
Primary screening
The preliminary screening for antibacterial activity using the cross-streak method. The antimicrobial activities of the isolates were tested by cross streak plate method employing nutrient agar medium for bacteria. The media were sterilised by autoclaving at 121 °c for 15 min. Then cool it into 40-45 °c and then poured into Petri plates and allowed to solidify. Each plate was streaked with one isolate of actinomycetes at the centre and incubated at 20 °c for 7 d after incubation, [6] test organisms were streaked perpendicular to the growth of the isolate; 24 h culture of bacteria. The bacterial Bacillus subtilis (MTCC-441), Proteus. Vulgaris (MTCC-426), Staphylococcus. Aureus (MTCC-3160), Klebsiella pneumonia (MTCC-2405), by using antibiotic agar diffusion method. Antibiotic activity of the test samples was measured upon these bacterial samples.
Secondary screening
Secondary screening of the isolates for antibiotic production was done using agar well diffusion method. Secondary screening of promising isolates was done by submerged fermentation slant cultures of mature actinomycetes strains were inoculated in the Starch Casein agar medium. The cultures were incubated in a rotary shaker (120 rpm) at 27o cfor 7 d and fermented broth was centrifuged at 10,000 rpm for 5 min. The clear supernatant samples were tested for their antimicrobial activity by agar well diffusion method, [7] to determine the antibacterial spectrum, pathogenic bacteria cultured on nutrient broth at 37 °cfor 24 h; the cultures were swapped on nutrient agar media. The relative activities of metabolites are determined based on the diameter of zones of inhibition formed [8].
Morphological and cultural characterization
The morphological characteristics of strain A-10 were examined by light and scanning electron microscopy of21-day-old cultures on starch casein agar. The coverslip technique (Zhou et al., 1998; Kawato and Shinobu, 1959) was used to observe hyphae and store chain morphology by light microscopy. Spore chain morphology and spore surface ornamentation were studied by examining gold-coated dehydrated specimens with aJeol model JSM 6610LV scanning electron microscope. Once cultures were sporulated, they were fixed using 1% Osmium tetroxide and dehydrated with ethanol series (20 to 100%). After dehydration, they were gold coated using SEM–Jeol, Japan for SEM studies. Cultural characteristics were observed on a number of agar media the following incubation at 28 °C for 14 d.
The Cultural Characterization of the Isolate was carried out using different media. Media used were those recommended by Shirling and Gottlieb in the International Streptomyces Project (ISP) and by Waksman. Mycelium was observed after incubation at 28 1C for 2 w. Colours were determined according to Prauser. Carbohydrate utilisation was determined by growth on carbon utilisation medium (ISP 9) supplemented with 1% carbon sources at 28 1C. Temperature range for growth was determined on inorganic salt starch agar medium (ISP 4) using a temperature gradient incubator. Hydrolysis of starch and milk were evaluated by using the media of Gordon et al. (1974). Reduction of nitrate and production of melanoid pigment were determined by the method of ISP. Liquefaction of gelatin was evaluated by the method of Waksman. All cultural characteristics were recorded after 14 d.
Table 1: No. of colonies isolated from samples collected near srikakulam coast
| Sample details | No. of colonies isolated | Colony characteristics |
| Sample 1 | 21 | Gray-11 White-6 Black-4 |
| Sample 2 | 14 | Gray-8 Black-4 Green-2 |
| Sample 3 | 16 | Gray-8 White-4 Black-3 Green-1 |
| Sample 4 | 17 | Gray-10 White-5 Black-2 |
Table 2: Antibacterial activity of the potential Actinomycetes isolates against the test organisms
Isolate |
Inhibition zone in diameter (mm) |
|||
Bacillus subtilis |
Proteus vulgaris |
Staphylococcus aureus |
Klebsiella pneumonia |
|
A-1 |
10 |
16 |
10 |
14 |
A-4 |
16 |
15 |
16 |
19 |
A-10 |
18 |
19 |
19 |
18 |
A-24 |
16 |
16 |
15 |
16 |
A-35 |
12 |
13 |
13 |
13 |
A-36 |
14 |
13 |
_ |
_ |
A-41 |
12 |
14 |
12 |
17 |
A-45 |
14 |
17 |
13 |
12 |
A-52 |
14 |
16 |
12 |
_ |
A-55 |
18 |
17 |
18 |
18 |
A-59 |
14 |
12 |
12 |
10 |
A-61 |
16 |
12 |
13 |
14 |
Fig. 1: SCA agar Isolation plates with actinomycetes colonies
Table 3: Growth and cultural characteristics of strain A-10
Agar medium |
Growth |
Colour of mycelium |
|
Aerial |
Substrate |
||
Yeast extract malt extract(ISP 2) |
+++ |
Grey |
Brown |
Oatmeal (ISP 3) |
++ |
Grey |
white Brown |
Inorganic salts/starch (ISP 4) |
+++ |
Grey |
Pale yellow |
Glycerol/asparagine (ISP 5) |
++ |
Dark grey |
Light yellow |
Tyrosine (ISP 7) |
++ |
Grey |
Light brown |
Czapek–Dox |
++ |
Whitish grey |
Brown |
Nutrient agar |
+ |
White |
Light yellow |
Modified Bennett’s |
+++ |
Grey |
Yellow |
+++, Good growth;++, moderate growth; +, poor growth

Fig. 2: Screening for antimicrobial activity against test organisms

Fig. 3: Scanning electron micrographs of A-10
RESULTS AND DISCUSSION
A limited scale survey of bioactive actinomycetes from marine sediment collected from coastal area Bay of Bengal [9]. During the course of our survey, 4 different samples were collected from different locations of Srikakulam Coast of Bay of Bengal. After Processing of the Samples in the Lab, we have isolated a total of 68 isolates from isolation plates with different pigment like grey, white, black, and green as shown in table 1. Further, we have screened all the isolate for antimicrobial activity. We have identified among all the isolated 12 isolates were found to be promising compared to other isolates. Further, we have concentrated our studies on these 12 isolates. In our Antibiotic screening studies i.e. primary and secondary screening, among twelve isolates isolate A-10 was found to be very much promising showing highest antibiotic activity against various gram-positive and negative bacteria. The antibiotic activity of all the isolates was shown in table 2. The crude extracts of the A-10 were subjected for secondary screening using disc diffusion methods. As shown in fig. 2 the isolate showed good antimicrobial activity against tested bacteria. Further, we have selected isolate A-10 for morphological and cultural characterization.
The Scanning Electron micrographs (JSM-6610LV) of isolate showed the isolate A-10, the spore chains were straight and with more than 20 spores per chain. The spores are cylindrical in shape and had a smooth surface. Whirls, sclerotic granules, sporangia and flagellate spores were not observed. As shown in fig. 3 Each spore chain has gray, spiral type spores which were cylindrical, 0.8–1.0µ mm X 1.2–1.3µ mm in size, having a smooth surface formed on a short (1.0 mm in diameter, 2.0 mm in length)conidiophore developed on the terminal of an aerial mycelium.
Chemotaxonomic investigations revealed that A-10 strain has cell wall type I which is characteristic of the genus Streptomyces. The physiological and biochemical characteristics of the isolate A-10 indicate that the isolate A-10 is aerobic, Gram-positive, non-acid-fast, mesophilic and shows limited degradative activities. It showed positive results for hydrolysis of starch and fat, haemolysis on blood agar and catalase production. The cultural characteristics of the isolateA-10 are shown in table 3. The isolate showed moderate to good growth in different media. Vegetative mycelium showed yellow-brown colour and aerial mycelium showed gray colour. It produced yellow-brown diffusible pigment in most of the media. The isolate was identified as Streptomyces sp.
Currently, the incidence of multidrug-resistant organisms is increasing and compromising the treatment of a growing number of infectious diseases [11]. As a result, there is an urgent need for developing a new drug which are effective against current antibiotic resistant pathogens. Actinomycetes have been proven as a potential source of bioactive compounds and the richest source of secondary metabolites [12]. The isolation of antibacterial components from the fresh water environment is of interest to isolate novel bioactive actinomycetes. Actinomycetes from 10% of the total bacteria are colonizing marine aggregates [13]. Marine habitat has been proven as outstanding and fascinating resources for innovating new and potent bioactive producing micro occurrence and distribution of antagonistic actinomycetes in the marine environment [14].
Recent investigation indicates the tremendous potential of marine actinomycetes particularly “streptomyces “species as a useful and sustainable source of new bioactive natural products [15]. The present study was aimed to isolate actinomycetes from marine environment and screen them for the production of secondary metabolites [16]. The medium was supplemented with tetracycline, and itraconazole to eliminate bacterial and fungal contaminations. The production of antibiotic substance is dependent on sea water [17, 18]. In this study SCA, agar was prepared using sterile sea water. In this, we have isolated and identified the actinomycetes on the surface of the agar plate. Actinomycetes are Gram-positive filamentous in nature.
During this screening of the novel secondary metabolites from unexplored regions of Bay of Bengal near Srikakulam Coast, we succeeded in isolating a good number of isolates. We also identified potent isolate A-10 among all the isolates. Thus, the result of this investigation revealed that the marine actinomycetes collected from the sediments of Bay of Bengal might be a potent source of novel antibiotics. The isolate was identified as Streptomyces sp. It is anticipated that isolation and screening of actinomycetes from these unexplored regions will be useful for the discovery of novel antibiotic for the welfare of human race.
CONCLUSION
The exploitation of marine actinomycetes as a source for novel secondary metabolites is in its infancy. Even with the limited screening efforts that have been dedicated to marine actinomycetes to date, the discovery rate of novel secondary metabolites from marine actinomycetes has recently surpassed that of their terrestrial counterparts, as evident by the isolation of many new chemical entities from marine actinomycetes.
Considering the outcome of the present findings, it was concluded that unexplored Srikakulam coast of Bay of Bengal is a rich source of driving economically important actinomycetes that are able to produce different bioactive compounds such as antibacterial compounds used for treatment against human pathogens. Further studies on the molecular characterization of the isolates and purification of the bioactive compounds are in progress.
ACKNOWLEDGMENT
The authors acknowledge Andhra University DST-PURSE central Instrumentation facility for the use of SEM to take Scanning Electron Micrographs of the Isolate.
CONFLICTS OF INTERESTS
All authors have none to declare.
REFERENCES
- Aparanji P, Venkataramana L, Murali Krishna R. Isolation of potent antibiotic producing actinomycetes from marine sediments of Andaman and Nicobar marine Islands. J Microbiol Antimicrobial 2013;5:6-12.
- Jaganmohan YSYV, Sirisha B, Haritha R, Ramana T. Selective screening isolation and characterization of antimicrobial agents from marine actinomycetes. J Pharam Pharm Sci 2013;5:443-9.
- Febina Bernice Saron S, Rachel Regi D, Shenbagarathai R. Screening of marine actinomycetes from coastal regions of Tamilnadu. Indian J Appl Res 2013;3:19-20.
- Sunillaxman A, Gaviraj N, Sifabdulrahimankarigar A, Ravindra K, Nagesh C, Chandra Shekara S. Screening, isolation and marine purification of antibacterial agents from marine actinomycetes. Int Curr Pharm J 2012;1:394-402.
- Gunasekaran M, Thangavel S. Isolation and screening of actinomycetes from marine sediments for their potential to produce antimicrobials. Int J Life Sci Biotechnol Pharm Res 2014;2:115-26.
- M Marine, P Arungao, G Ebmer Bon, Maceda, F Marine Angelica, Villano. Screening of antibiotic–producing actinomycetes from marine, Brackish and terrestrial sediments of a small island, Philippines. J Res Sci Computing Eng 2007;4:29-38.
- Vijayakumar R, Panneerselvam K, Muthukumar C, Thajuddin N, Panneerselavan A, Saravanamuthu R. Optimization of antimicrobial production by marine actinomycetes streptomyces. Afghaniensis VPT53-1 isolated from palk strait, East coast of India. Indian J Microbiol 2012;52:230-9.
- Benita Mercy R, krishnankanna B. Antimicrobial activity of streptomyces albafaciens against methicillin resistant staphylococcus aureus and vancomycine resistant species. Res J Pharm Biol Chem Sci 2013;4:1248-57.
- Dubey RC, Maheswari DK. Practical Microliology; 2015. p. 55-7.
- Chinnanarasaiah B, Leelavathi V, Sudhakar G, Mariyadasu P. Isolation identification and molecular characterization of actinomycetes strain from the laterite soil of kandukuru. Int J Recent Sci Res 2014;5:2236-43.
- Yaminisudha Lakshmi S, Hharithalaksmi D, Sharmila S. Isolation, screening, identification, characterization and application green synthesised silver nanoparticle from marine actinomycetes streptomycesalthioticus. W J Pharm Res 2015;4:1592-611.
- Vidyasr N, Yamini Sudha Lakshmi S. Isolation, screening, identification, charecterization and application green synthesized silver nanoparticle from marine actinomycetes (Streptomyces Griese Rubens). W J Pharm Res 2015;4:1801-20.
- Jensen PR, Gontang E, Mafnas C. Culturable marine actinomycete diversity from tropical pacific ocean sediment. Environ Microbiol 2005;7:1039-48.
- Rabbani M, Sadeghi HM, Kajro Z. Molecular detection of streptomyces griseus isolated from soil. Pak J Biol Sci 2007;10:3374-9.
- Valli S, Suvathi S, Aysha O. Antimicrobial potential of actinomycetes species isolated from marine environment. Asian Pac J Trop Biomed 2012;2:469-73.
- Mojtaba M, Hamed N, Javad H, Aboulghasem R. Screening of antibactetial producing actinomycetes from sediments of Caspian sea. Int J Med Curr Microbiol 2013;2:64-71.
- Sujatha P, Bapiraju VVSN, Ramana T. Studies on antagonistic marine actinomycetes from the bay of Bengal. World J Microbiol Biotechnol 2005;2:583-5.
- Kin S, Lam T. Discovery of novel metabolites from marine actinomycetes. Curr Opin Microbiol 2006;9:245–51.
How to cite this article
- Sujatha Peela, Swethalatha Porana. Isolation and screening of novel streptomyces from sediments of the Bay of Bengal near Srikakulam coast. Int J Curr Pharm Res 2017;9(1):40-44.